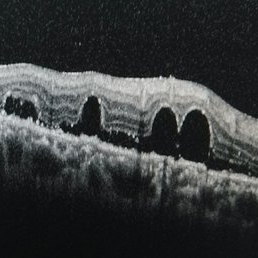

-
Perfluorooctane Drops Under the Retina
Perfluorooctane Drops Under the Retina
Aug 20 2014 by Jinfeng Qu
Perfluorooctane drops under the retina.
Condition/keywords: perfluorooctane
-
 Valsalva Retinopathy
Valsalva Retinopathy

A project from the American Society of Retina Specialists